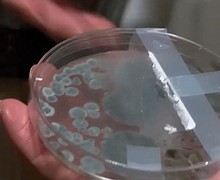

League City native supports U.S. Navy Helicopter Maritime Strike Squadron
Petty Officer 2nd Class Thomas Dill, a native of League City, Texas, serves the U.S. Navy assigned to Helicopter Maritime Strike Squadron (HSM) 49.
Empowering Women: Charlotte Mayor Vi Lyles and Wells Fargo EVP Georgette Dixon Shine at NAREB Convention
In a celebration of women's remarkable societal contributions, Charlotte Mayor Vi Lyles and Wells Fargo EVP Georgette Dixon took center stage at the National Association of Real Estate Brokers (NAREB) Midwinter Convention. Wells Fargo proudly sponsored the session, underscoring its …
Justice Served: Armed Robber Who Fatally Shot Clerk Receives Life Sentence
In a landmark ruling, the perpetrator behind the tragic 2019 convenience store robbery, which resulted in the untimely death of a beloved clerk, has been sentenced to life in prison for murder. Harris County District Attorney Kim Ogg delivered the …
Mortgage rates drop after climbing for four weeks
Mortgage rates ticked down slightly this week, a tiny boon to buyers eager to make a move with newly listed homes coming to market.
Congress explores new bill to force sale/ban of TikTok in America
A new bill that could ban TikTok from all US phones and tablets is set for a vote by a key House committee on Thursday, reflecting renewed bipartisan efforts to respond to national security concerns linked to the popular app.
EMS Grady becomes first Atlanta paramedics to give blood transfusions in the field
Starting in March, EMS Grady paramedics will begin administering blood transfusions in the field for patients who suffer severe trauma where major blood loss occurs.
Israel: Gazans condemed to starvation; newborns die of hunger; mothers struggle to feed their children
Anwar Abdul Nabi perches on the edge of a bed at the Kamal Adwan Hospital in northern Gaza. Her eyes are sunken with grief.
Swifties step in - help pay for Florida's woman's wedding
What lengths would you go to to help pay for your wedding? One Tampa woman considered potentially selling her beloved guitar, signed by Taylor Swift.
Prosecutor: Hollywood Casino armed robbery suspect held multiple employees at gunpoint
A man has been formally charged with armed robbery, kidnapping and multiple other charges after an attempted armed robbery caused chaos at the Hollywood Casino in Lawrenceburg over the weekend.
Germany gripped by strikes; Lufthansa hurts
Germany’s biggest airline has warned that ongoing strikes by thousands of its ground staff and airport workers could hurt its earnings this quarter, after walkouts earlier this year already cost the company more than $100 million.
TSA’s new experiment: Self-service security checks
Self-checkout annoys many grocery shoppers and causes problems that are prompting numerous major retailers to pull back on using it. But that’s not stopping the Transportation Security Administration from testing a self-service screening system at Harry Reid International Airport in …
Oakland A’s vision: Las Vegas ballpark draws comparisons with Sydney Opera House/armadillo
The Oakland Athletics have released renderings of their new, 33,000-seat ballpark on the Las Vegas Strip, which is set to be canopied by an enormous, five-tier roof.
What to expect in Friday’s jobs report
Don’t be surprised if Friday’s jobs report shows that February’s employment gains were far below those reported for January.
Customers pull their cash from NYCB, but no bank run
Customers of New York Community Bank (NYCB) pulled $6 billion worth of deposits between February 5 and March 5, leaving the bank’s deposit base 7% lower, at $77 billion.
Woman says mold forces her out of Overland Park apartment
Stephanie Gailliaert says she’s been living at Village of Lionsgate Apartments for the last six months, but now is looking to move out.